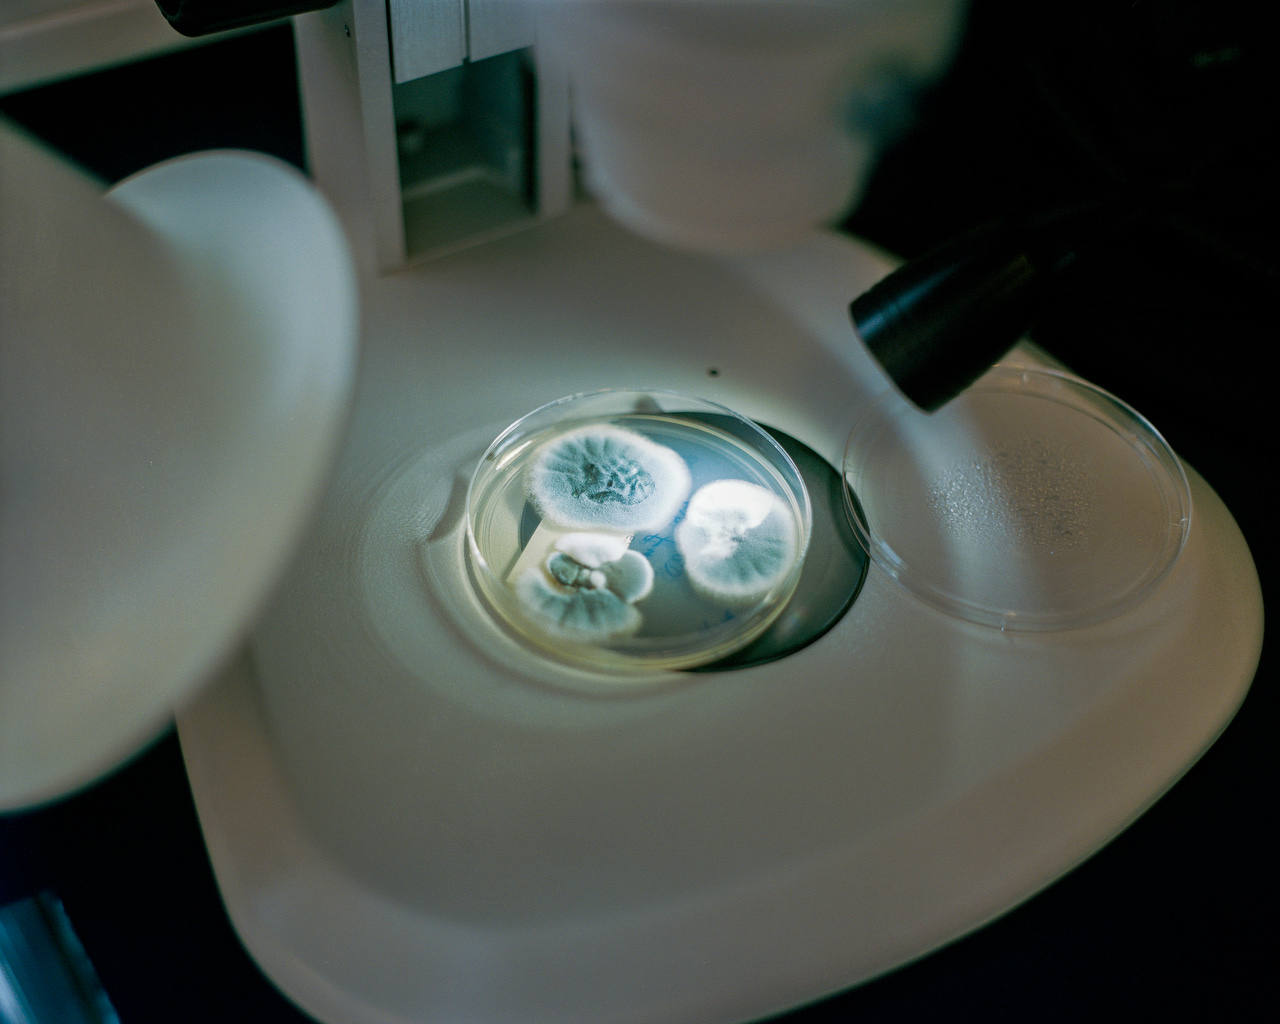

Using this formula, the Danish Emergency Management Agency (DEMA) has identified and mapped the 13 greatest threats facing Denmark today.
This project examines how the Danish government works to protect the country’s 5.8 million residents from these 13 identified threats, exploring the strategies, preparedness measures, and emergency responses designed to safeguard the nation.

THREAT #1: SPACE WEATHER
The Sun constantly emits vast amounts of energy into space in the form of the solar wind. Although this radiation can be harmful to human health, life on Earth is largely shielded by the planet’s magnetic field and the outer layers of the atmosphere.
Occasionally, however, violent eruptions occur in the Sun’s atmosphere. When the intensified solar wind reaches Earth, it interacts with the magnetic field. A beautiful and harmless result of this interaction is the aurora borealis, or Northern Lights. In some cases, though, the disturbances induce powerful electric currents in conductive materials. The most vulnerable are the long, high-voltage transmission lines in our electrical grid.
The most powerful solar storm ever recorded took place in 1859. Known as the Carrington Event, it electrocuted telegraph operators in Canada, sparked fires in telegraph stations, and caused auroras to appear far from the poles, in countries such as Senegal, Mexico, Cuba, and Colombia.
Today, space weather poses an even greater risk because of our reliance on technology. Around 1,300 operational satellites orbit Earth, all of which are susceptible to solar storms. For example, on November 4, 2015, a solar flare disrupted radar systems in Sweden, forcing authorities to temporarily close the nation’s airspace.


Engineer Lars Pedersen is calibrating the geomagnetic reference point, also known as point zero. The device measures geomagnetic radiation from the Sun as it reaches Earth, helping to predict magnetic shockwaves that could cause electronic disturbances. To minimize interference from high-voltage sources, the device is installed in the countryside, far from urban infrastructure.








The Space Department at the Technical University of Denmark (DTU Space) is responsible for the Danish space programme and is leading an international satellite mission called Swarm. The mission aims to map Earth’s magnetic field with unprecedented precision. DTU Space developed the magnetometers used for these measurements. Swarm is part of the European Space Agency’s Living Planet programme.



When rehearsing oil-accidents, the marine uses popcorn to imitate oil. The popcorns behave similar to oil when thrown in the water.
THREAT #2: MARITIME ACCIDENTS
With roughly 7,300 kilometers of coastline, Denmark faces significant risks from maritime accidents. Such incidents represent one of the greatest threats to the country.
Each year, about 36,000 merchant ships pass through the Øresund, while just over 27,000 transit the Great Belt. Among these are approximately 5,500 tankers carrying crude oil. Accidents involving oil spills can spread rapidly, causing severe damage to marine ecosystems, coastal environments, and the economy.
The largest accident in recent history occurred in March 2001, when an oil tanker collided with a freight ship in Denmark’s southeastern waters. The spill released 2,350 tons of heating oil into the sea, leading to the deaths of more than 20,000 birds.


The button that activates the maritime warning system, and a telegraphist from Lyngby Radio. Lyngby radio have facilitated telecommunication between land and sea since 1923. The search and rescue team operates almost daily, and works out of a 2nd world war underground bunker in the east of Denmark.
THREAT #3: DISEASES OF HIGH VIRULENCE
Denmark’s most important weapon in the fight against pandemics is knowledge.
Over the years, Danish society has built national registers containing information about the entire population. Since the introduction of the civil registration number in 1968, it has been possible to follow every citizen from cradle to grave. This provides a unique foundation for research.
The national biobank, covering 2,400 square meters, is one of the largest in the world. It contains several million biological samples collected from the health care system, which can be linked with the data in the national registers. This combination forms a resource that is unique even by international standards, offering enormous benefits for research into the causes, prevention, and treatment of diseases.
Denmark’s childhood vaccination program is another key reason why highly virulent—that is, highly contagious and dangerous—diseases are rare. However, even small declines in vaccination coverage can weaken herd immunity and leave the population vulnerable.

A young girl is receiving the HPV vaccine, which is the major cause of cervical cancer. The HPV vaccine has been surrounded by wrong facts and bad press, which has lead to only 28 percent of girls born in 2004 to receive the vaccine, down from 79 percent in 2000.

The hand of a health inspector touches a nuclear reactor silo, that is the last out of three research silos that is being decommissioned at the Risø nuclear facility.
THREAT #4: NUCLEAR INCIDENTS
Although Denmark does not have any nuclear power plants, three research reactors were previously operated at the Risø Research Facility near Roskilde. One of these reactors still remains and is currently being dismantled.
Approximately 10,000 cubic meters of radioactive waste are stored at Risø. Most of this waste consists of construction materials, protective clothing, and other items that have been exposed to ionizing radiation. The fuel elements themselves are returned to the United States under the terms of the original purchase agreement. However, no decision has yet been made regarding the establishment of either an interim storage facility or a permanent repository for the waste.
Across Europe, more than 170 reactors are in operation, about 75 percent of which are located closer to Denmark than Chernobyl in Ukraine—the site of the world’s most serious nuclear accident in 1986. The nearest reactors are in Sweden, only 65 kilometers from Denmark. In the event of a nuclear incident, health personnel at Risø would play a crucial role in emergency response efforts.





Denmark's warning sirens are tested every night without sound, but once a year - the first Wednesday in May at 12.00 - they are tested with full sound. The Danish Emergency Management Agency and the National Police test the sirens to test the entire system, but also to remind the population of the sirens' use and significance.
The physical activation takes place from a computer at the East Jutland Police in Aarhus (right).


"Open the cabinet, lift the phone, wait". In North Zealand lies the shelter Regan East, a two-part shelter built to function as a residence and workplace for selected government officials, the royal family and the central administration in the event of a threatening military attack on Denmark.

THREAT #5: TRANSPORT ACCIDENTS
Transport accidents include incidents both in the air and on the ground.
In Europe, an average of 25,000 to 30,000 flights are operated every day. Air transport is statistically the safest mode of travel, and fatal aviation accidents are rarely seen in Denmark. Globally, the number of fatal air accidents has been declining, despite significant growth in air traffic over the past decade. In 2015, Copenhagen Airport recorded a record 26.6 million passengers.
In the same year, 178 people were killed in 172 road accidents in Denmark. By comparison, in 1971, the highest number ever recorded, 1,213 people lost their lives on Danish roads. This figure included many smaller-scale accidents.
Road accidents involving more than two fatalities are uncommon. Speed limits, traffic enforcement, road design improvements, clearer signage, and above all, advances in vehicle safety have contributed to reducing the number of fatalities. Nevertheless, transport accidents remain one of the leading causes of accidental deaths in Denmark.




Above: Road signage near Stevns on Zealand. Below: Practise grounds for rescuing people from car accidents in southern Jutland.

Office space at The Danish Meteorological Institute; DMI


A skatepark in Roskilde that also collects wastewater during cloudbursts.









Left: In the spring of 2016, DMI acquired a new supercomputer, which plays an invaluable role in the Danish emergency preparedness. To save money on the cooling of this, they chose to put it in Iceland. In the basement at DMI, there are now servers that are mirrored with the supercomputer twice a day. Right: A chalk mining ground with a DMI measuring station in the background at Stevns.

HREAT #7: ANIMAL DISEASES
Food and livestock production can be exposed to a number of serious contagious diseases. These primarily pose a threat to the animals themselves, but in some cases humans may also become infected, leading to significant socio-economic consequences.
Livestock production in Denmark mainly involves cattle, pigs, sheep, and poultry. In 2014, the value of livestock production amounted to DKK 51.8 billion, corresponding to approximately 25 percent of Denmark’s total goods exports. Even minor outbreaks—whether quickly brought under control or later revealed to be false alarms—can have serious consequences for the agricultural sector and trade.
In November 2020, during the COVID-19 pandemic, Denmark culled around 17 million mink after outbreaks were detected at more than 200 farms. The culling aimed to prevent the spread of new virus mutations.

Two men working at Tivoli in Copenhagen, which has a daily fireworks show, are eating breakfast at a smoke divers course. The demands to security in companies handling dangerous substances like these are high.
THREAT #8: ACCIDENTS WITH CHEMICAL SUBSTANCES
Accidents involving chemical substances occur when hazardous materials cause danger through fire, explosion, or spillage. Many types of high-risk companies handle such substances. Oil depots and refineries are among the largest, but fireworks facilities have also historically posed a significant risk.
The accident at the fireworks factory in Seest near Kolding on 3 November 2004 was the largest industrial accident in Denmark in recent times in terms of material damage. The incident is believed to have started when an employee dropped a box of rockets, which subsequently ignited.
Around 800 people took part in combating the fire, including approximately 350 firefighters, 150 police officers, and 300 members of the Home Guard. Twelve companies were later demolished, and about 350 private houses were damaged—many of them either completely destroyed by fire or left uninhabitable.


Left: A honorary firefighter at Amager firestation in Copenhagen. Knowledge and education is key to preventing accidents. Right: Training facility for the National Preparation Board in southern Jutland, where the drafted men and women are trained to become emergency firefighters.

Danish drinking water is almost solely dependent on groundwater, and big afforestations helps to secure its cleanliness. Vestskoven in Alberstlunds is the biggest new forest in Denmark.
THREAT #9: WATER- AND FOOD-BORNE DISEASES
Water- and food-borne diseases are caused by contamination with a wide range of microorganisms, including bacteria, viruses, parasites, and fungi.
In the summer of 2014, Denmark experienced its deadliest recorded food-borne outbreak. A total of 41 people were infected with listeria, and 17 died as a result. Genetic analyses of the bacteria were crucial in tracing the source quickly and most likely prevented further infections.
Reading the genetic code of DNA is called DNA sequencing. This can involve sequencing a single section of a gene or the entire genome of an organism. Since the first genome was sequenced in 1976, technological advances have made the process vastly faster, to the point where billions of DNA bases can now be sequenced within hours. In the case of listeria, this means that the order of all 2.9 million DNA building blocks in the bacterial genome can be determined with precision.
The World Health Organization estimates that food-borne infections cause around 23 million cases of illness every year in the EU.

The machine that sequences genomes at The Danish Serum Institute. The first bacterial genome was read in 1955, the first viral genome in 1976 and the first human genome after 10 years of work in 2001.


Training with new members of the Danish Emergency Management Agency. If a given storm or other incident is of a sufficiently serious nature, they intervene from on of their 5 strategically located centers in Denmark.
THREAT #10: HURRICANES AND STRONG STORMS
In the past 100 years, only five hurricanes have been recorded in Denmark, though several storms have produced gusts of hurricane strength. Between 1950 and 2015, the Danish Meteorological Institute (DMI) registered 45 storms and hurricanes affecting the country. While strong winds cannot be prevented, advances in forecasting have made it increasingly possible to issue timely warnings, and there is solid knowledge of the consequences that hurricanes and severe storms can cause.
Low-pressure systems in the atmosphere can lead to strong winds at the Earth’s surface. As weather models and supercomputers continue to improve, forecasts of these systems become more precise. Although storms and hurricanes rarely arrive without warning, predicting their exact path and intensity remains a challenge. This uncertainty is one reason why large parts of the Danish electricity grid have been placed underground to reduce vulnerability.
On 3–4 December 1999, Denmark experienced its most powerful hurricane on record. With the exception of North Jutland, gusts reached 40–50 m/s across much of the country. The storm caused the deaths of seven people, injured more than 800 others, and resulted in material damages estimated at 13 billion DKK. Nearly four million cubic meters of timber were lost, and around 400,000 households were left without power.
Today, storm damage remains a widespread issue. Approximately one in ten Danish homeowners has experienced storm-related damage within the past five years.

In Denmark, mandatory military draft has more or less existed since the times of the vikings. In 1849 a national tombola system was introduced, which is by and large still in place today. Men are drafted when they turn 18, women can volunteer. There's drafting sessions every day, all year round. Many drafted young people choose to serve in the Danish Emergency Management Agency.

A young man is having a medical check at military draft session. The Danish Emergency Management Agency has conscripts at barracks located in Thisted, Herning, Haderslev, Næstved and Allinge. There is currently a waiting list to perform military service in all places.

Rapeseed field with a dike ind the background at the Wadden Sea.
THREAT #11: FLOODS FROM THE SEA
Denmark has an average elevation of 31 meters above sea level and a coastline of approximately 7,300 km. Flooding from the sea occurs when water levels rise high enough to inundate urban and rural areas.
Strong winds can push large volumes of seawater inland, creating storm surges. These are most common along the North Sea and the Wadden Sea coasts. In inland waters, such as marshlands and fjord areas, winds can push surface water further inland, causing significant flooding.
Storm surges occur almost every year.
The oldest dikes in Southern Jutland date back to the First World War, when Russian prisoners of war were used to build them.


A dike digger and his dog living in The Wadden Sea in the southwest of Denmark. The people living here are some of the most adapt towards wind and flooding. There is more than 500 km of dykes stretching from Netherlands to Denmark.